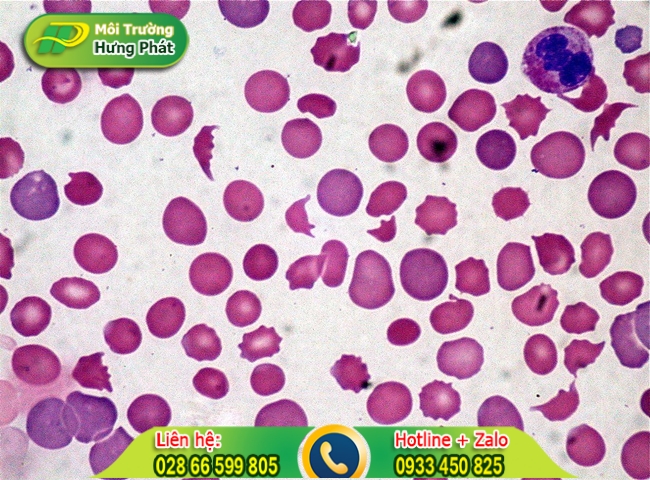
Lượng bạch cầu &aacute;i toan tăng cao

Tiêu chảy, tả là một trong những bệnh lý dễ mắc phải khi ăn uống, sinh hoạt không điều độ. Căn bệnh này có đặc điểm là dễ lây lan từ người qua người. Vậy nên trong gia đình nếu có người bị tiêu chảy, tả thì chúng ta cần dọn nhà vệ sinh cẩn thận để tránh lây lan cho các thành viên khác.

Dọn dẹp toilet khi trong nhà có người tiêu chảy
Tiêu chảy là một loại bệnh dễ nhận biết vì xuất hiện tình trạng đi ngoài ra phân lỏng. Khi bị mắc bệnh này, người bệnh sẽ có số lần đi ngoài nhiều gấp nhiều lần người bình thường.
Đây là một loại bệnh gây mất nước rất nguy hiểm, có thể gây tử vong cho người bệnh. Hiện nay loại bệnh này được chia thành 3 loại chính: tiêu chảy cấp, tiêu chảy bán cấp và tiêu chảy mãn tính.

Dấu hiệu bệnh tiêu chảy cấp
Để biết được trong nhà có người bị tiêu chảy, tả hay không thì các bạn hãy tham khảo qua một vài dấu hiệu sau đây:
✅ Người bệnh thường có dấu hiệu bụng đau âm ỉ và có triệu chứng buồn nôn hoặc nôn mửa.
✅ Đi ngoài ra phân lỏng. Màu sắc phân khác thường và đôi khi còn có máu.
✅ Người bệnh tiêu chảy thường ăn uống không ngon miệng, dễ cảm thấy đau đầu.
✅ Trong nhiều trường hợp xuất hiện tình trạng tiêu són hoặc món rặn khi đi vệ sinh
✅ Phát sốt và khát nước liên lục do tình trạng đi ngoài nhiều gây mất nước.

Người bệnh bị sốt cao
Thực chất, tiêu chảy được coi là một cách mà cơ thể loại bỏ vi trùng có hại ra khỏi cơ thể. Bình thường bệnh này sẽ bắt đầu và kéo dài từ vài ngày cho đến một tuần.
Khi tình trạng tiêu chảy xảy ra nhiều lần sẽ kèm theo các triệu chứng nôn mửa, sốt, chuột rút và mất nhiều nước. Sau đây là các lý do phổ biến hình thành bệnh tiêu chảy cấp:
✔️ Nguyên nhân phổ biến nhất là nhiễm virus tiêu chảy. Một số virus có thể gây tiêu chảy cấp là: virus rotavirus, salmonella hoặc ký sinh trùng như giardia…
✔️ Bị ngộ độc thực phẩm do ăn các thực phẩm, thức ăn không hợp vệ sinh. Khi bị tiêu chảy, các triệu chứng sẽ xuất hiện rất nhanh và dữ dội. Tuy nhiên chúng có xu hướng hết trong vòng 1 ngày.
✔️ Hội chứng ruột kích thích cũng là một trong những nguyên nhân gây nên tiêu chảy. Ngoài ra còn có thể do các bệnh như Crohn, bệnh Celiac… hoặc do cơ thể thiếu kẽm.
✔️ Một nguyên nhân khác là do rối loạn tiêu hóa bạch cầu ái toan. Biểu hiện của tình trạng này là số lượng bạch cầu ái toan trong hệ thống tiêu hóa tăng cao.
Xem thêm: Những cách vệ sinh bồn cầu sạch khuẩn
Lượng bạch cầu ái toan tăng cao
Mặc dù tiêu chảy, bệnh tả là một căn bệnh có thể tự điều trị tại nhà nhưng nếu không điều trị tận gốc trong thời gian nhất định sẽ gây nên những ảnh hưởng xấu cho sức khỏe.
Vì vậy, khi các bạn đã áp dụng các phương pháp chữa trị tại nhà nhưng không có kết quả thì phải lập tức đến bệnh viện để được thăm khám kịp thời. Dưới đây là các biểu hiện của người bị tiêu chảy cần được điều trị tại bệnh viện:
✅ Cơ thể người bệnh bị mất nước nghiêm trọng và luôn đau bụng, cảm thấy khô miệng và khát nước liên tục.
✅ Nước tiểu người bệnh chuyển màu sẫm và thường xuyên cảm thấy chóng mặt, không muốn đi vệ sinh.
✅ Khi đi đại tiện thì phân có màu đen đi kèm theo máu và chất nhầy.
✅ Có triệu chứng sốt cao và những cơn đau bụng quằn quại ngày càng tăng dần.

Tình trạng đau quặn bụng tăng dần
Tiêu chảy là một loại bệnh lý dễ lây lan đặc biệt là trong khu vực nhà vệ sinh. Do đó, chúng ta cần đặc biệt chú trọng tới việc dọn dẹp toilet khi trong nhà có người mắc bệnh này.
Việc vệ sinh toilet sạch sẽ không chỉ đảm bảo an toàn vệ sinh mà còn ngăn ngừa tình trạng lây lan bệnh cho các thành viên khác trong gia đình, tránh hình thành ổ dịch nghiêm trọng.
Khi dọn dẹp toilet tại gia đình có người mắc tiêu chảy, chúng ta nên tuân theo các nguyên tắc sau:
✔️ Việc dọn dẹp, làm sạch nhà vệ sinh nên được thực hiện từ trên cao xuống dưới thấp để tránh mang vi khuẩn từ dưới lên.
✔️ Vệ sinh dọn rửa theo nguyên tắc từ ngoài cửa vào trong, từ xa lại gần.
✔️ Nên làm sạch tại các khu vực sạch đầu tiên rồi mới đến các khu vực bẩn. Điều này sẽ hạn chế mang vi khuẩn phát tán rộng ra.
✔️ Không nên sử dụng chung dụng cụ vệ sinh khu vực sạch và khu vực bẩn. Chúng ta cần đổi dụng cụ hoặc thay mới trước khi thay đổi vị trí dọn dẹp.
✔️ Nên dọn dẹp theo nguyên tắc diện tích làm sạch của khu vực này luôn chồng lên 1 phần diện tích của khu vực trước đó. Thực hiện làm hết khu vực này mới tiến hành tới khu vực khác, làm đến đâu thì phải sạch đến đó.

Dọn dẹp sạch sẽ từng khu vực một
Trong mỗi gia đình, việc dọn dẹp nhà vệ sinh đã không còn quá xa lạ. Tuy nhiên, khi trong nhà có người bị tiêu chảy thì quy trình làm sạch nhà vệ sinh này cần được thực hiện kỹ càng hơn bình thường rất nhiều.
Điều trước tiên chúng ta cần làm chính là chuẩn bị những dụng cụ dọn rửa cần thiết. Sau đây là một số đồ dùng hỗ trợ cho quá trình dọn dẹp dễ dàng và đơn giản hơn:
✅ Bàn chải mềm, miếng bọt biển, khăn lau mềm, miếng có bằng nhôm: Đây là các đồ vật cần thiết để lau chùi các khu vực trong nhà vệ sinh.
✅ Dung dịch tẩy rửa chuyên dụng: Sử dụng các chất tẩy rửa là điều cần thiết để làm sạch và diệt khuẩn hiệu quả. Các loại dung dịch này sẽ bao gồm hóa chất tẩy mốc, lau sàn, lau bồn rửa mặt, dung dịch cọ toilet, dung dịch khử khuẩn…
✅ Chổi gạt, xô nước: Đây là 2 dụng cụ không thể thiếu để dọn dẹp các khu vực cửa kính, gương.
✅ Găng tay, khẩu trang, kính mắt, ủng cao su: Việc sử dụng đồ bảo hộ là vô cùng cần thiết để tránh tiếp xúc với các loại hóa chất. Đặc biệt khi trong nhà có người bệnh thì những đồ dùng này sẽ giúp hạn chế tiếp xúc và mang vi khuẩn ra ngoài.

Dụng cụ vệ sinh toilet
Sau khi đã chuẩn bị xong các vật dụng cần thiết, chúng ta sẽ đi tìm hiểu các bước dọn dẹp toilet đạt chuẩn
Công tác chuẩn bị dọn dẹp toilet
Đầu tiên, chúng ta cần bỏ các vật dụng không cần thiết trong quá trình dọn dẹp như quần áo, các loại sữa tắm, sữa rửa mặt… để tránh gây cản trở trong khi dọn dẹp.
Tiếp theo chúng ta sẽ đổ một ít thuốc tẩy hoặc chất khử trùng vào bồn cầu và đậy nắp lại. Vì các chất tẩy rửa cần thời gian từ 20 - 30 phút để hoạt động nên hãy thực hiện ở giai đoạn chuẩn bị để tiết kiệm thời gian hơn nhé.
Cần lưu ý phủi bụi trên các đồ dùng và khu vực vệ sinh để việc dọn dẹp được dễ dàng và tránh phát tán vết bụi bẩn.

Phủi bụi trước khi dọn dẹp
Dọn dẹp nhà vệ sinh theo các khu vực
Trong bước này, chúng ta sẽ lần lượt làm sạch các vị trí và khu vực trong nhà vệ sinh.
✔️ Lau tường nhà vệ sinh: Tường nhà vệ sinh nên được làm sạch với dung dịch tẩy rửa và dùng khăn mềm, bọt biển để lau khô. Nếu có xuất hiện các đốm ẩm mốc thì bạn hãy sử dụng Javel để có hiệu quả nhanh chóng.
✔️ Lau kính, gương soi nhà vệ sinh: Kính, gương soi cũng là những nơi dễ bám bẩn và vi khuẩn. Các bạn hãy dùng khăn khô nhúng vào dung dịch lau kính để vệ sinh chúng nhé. Trong trường hợp kính không quá bẩn thì chúng ta có thể xịt trực tiếp dung dịch để làm sạch chúng.
✔️ Vệ sinh các nội thất trong nhà vệ sinh: Các nội thất như vòi sen, bồn rửa mặt, giá/kệ đựng đồ cũng nên được làm sạch để đảm bảo an toàn cho sức khỏe người sử dụng và tăng tuổi thọ của chúng.
✔️ Làm sạch bồn cầu: Đây là khu vực cần được thực hiện vệ sinh cẩn trọng do chứa nhiều vi khuẩn gây bệnh.

Làm sạch bồn cầu cẩn thận
Với các khu vực bên ngoài như tay cầm xả nước, các mặt bồn cầu thì nên làm sạch với khăn khô nhúng dung dịch tẩy rửa. Khu vực bên trong bồn cầu trước đó đã được ngâm với hóa chất thì chúng ta sẽ làm sạch với cọ chà bồn cầu rồi xả lại với nước sạch là xong.
✔️ Mặt sàn nhà vệ sinh: Sàn nhà cũng là khu vực cần được làm sạch cẩn thận. Chúng ta nên sử dụng dung dịch tẩy rửa chuyên dụng cho sàn nhà để làm sạch hoàn toàn.
Cần cẩn thận tránh để nước đọng lại trong các vị trí chân tường vì sẽ dễ gây hiện tượng rêu, nấm mốc phát triển và tạo điều kiện thuận lợi cho các vi khuẩn sinh sôi.
Hoàn tất dọn dẹp nhà vệ sinh
Sau khi hoàn tất dọn dẹp thì nên mở cửa sổ, cửa thông gió hoặc quạt thông gió để khu vực nhà vệ sinh khô thoáng và bay hết mùi của các dung dịch tẩy rửa.

Mở cửa sổ để nhà vệ sinh khô thoáng
Điều đặc biệt quan trọng để tránh lây lan căn bệnh tiêu chảy trong gia đình chính là dọn nhà vệ sinh cẩn thận. Qua các thông tin và quy trình dọn dẹp toilet chi tiết trên đây, chúng tôi mong rằng các bạn sẽ tránh được sự hình thành và lây lan của virus tiêu chảy.
Tags: nguyên tắc dọn dẹp nhà vệ sinh, cách làm sạch toilet, mẹo dọn nhà vệ sinh hiệu quả, vệ sinh toilet đơn giản, phương pháp làm sạch toilet nhanh chóng